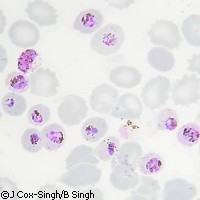

Científicos secuencian los genomas de dos parásitos de la malaria
Dos equipos internacionales de científicos han logrado secuenciar los genomas de dos importantes parásitos de la malaria: el Plasmodium vivax y el Plasmodium knowlesi. Sus hallazgos ponen de relieve las similitudes y diferencias que existen entre las distintas especies de Plasmodium causantes de la malaria y podrían conducir al desarrollo de nuevos medicamentos y vacunas contra esta mortal enfermedad. La malaria es causada por parásitos del género Plasmodium que son transmitidos de un humano a otro por ciertos mosquitos. Se conocen al menos cinco especies de Plasmodium que causan la malaria en humanos: P. falciparum, P. vivax, P. ovale, P. malariae y P. knowlesi. Aproximadamente tres cuartas partes de los casos y el 90% de las muertes por malaria se deben al P. falciparum, cuyo genoma fue secuenciado en 2002. Ahora, en estos nuevos estudios publicados en la revista Nature, los científicos desvelan los genomas del P. vivax, que es la segunda cepa más mortal de la enfermedad, y del P. knowlesi, que está cobrando relevancia como causa de la malaria en humanos, sobre todo en el Sureste asiático. El P. vivax es el principal causante de la malaria fuera de África; alrededor de 2.600 millones de personas, concentradas principalmente en Asia y Latinoamérica, corren el riesgo de contraer la enfermedad. A diferencia del P. falciparum, el P. vivax se ve especialmente favorecido por los climas templados y las épocas de menos calor. Aunque es infrecuente que sea mortal, la infección por el P. vivax se caracteriza por episodios reiterados de enfermedad que pueden prolongarse varios meses. Cada vez resulta más difícil tratar los casos de malaria por P. vivax debido a su creciente resistencia a los fármacos existentes. El análisis del genoma del P. vivax revela la existencia de familias genéticas que permiten al parásito penetrar en los glóbulos rojos de la sangre por rutas antes desconocidas. También se descubrieron genes relacionados con el estado de letargo del virus, información que puede servir para diseñar fármacos con los que manipular dicha fase. «Las recaídas por Plasmodium vivax representan un complicado reto para los científicos y los médicos en particular», afirmó Anthony Fauci, del Instituto Nacional de Alergias y Enfermedades Infecciosas de Estados Unidos (NIAID). «La secuenciación completa del genoma del P. vivax abre la puerta a nuevos descubrimientos sobre la biología de la malaria por vivax y da pistas para dar con nuevos tratamientos y vacunas.» En Nature se ha publicado un segundo artículo donde se describe el genoma del P. knowlesi. El huésped natural de esta cepa es el macaco cangrejero o de Java, pero cada vez son más los casos humanos detectados, sobre todo en el Sureste asiático. Actualmente se cree que muchos casos humanos de malaria que antes se atribuían al P. malariae se deben realidad al P. knowlesi. Ambas cepas son difíciles de distinguir con un simple microscopio. Como ha ocurrido con el genoma del P. vivax, el del P. knowlesi ha deparado varios hechos sorprendentes. Por ejemplo, tiene genes que parecen imitar a los genes humanos implicados en la regulación del sistema inmunitario. Los científicos sospechan que estos genes del parásito permiten al P. knowlesi mermar la capacidad del huésped humano de reconocer los glóbulos infectados. «Nuestro estudio ilustra el poder que nos otorga la secuenciación de nuevos genomas de la malaria, de cara a descubrir aspectos biológicos fascinantes y aún desconocidos de los parásitos que la provocan», apuntó el Dr. Arnab Pain del Wellcome Trust Sanger Institute, quien también está trabajando en la secuenciación de los genomas de las dos especies restantes de Plasmodium que se sabe infectan a humanos. «Curiosamente, los genes que, según creemos, ayudan al parásito de manera decisiva a evitar ser detectado y destruido por las defensas del huésped, están diseminados por todo el genoma. En las otras especies que hemos estudiado, estos genes casi siempre se situaban en los extremos de los cromosomas.» «Es la primera vez que vemos el genoma de un parásito causante de malaria en monos. Nos ha deparado nuevas incógnitas y también sorpresas, así como nuevos recursos para combatir la malaria», añadió el Dr. Alan Thomas del Centro de Investigación Biomédica sobre Primates, en Rijswijk (Países Bajos). «El P. knowlesi está estrechamente relacionado con la segunda causa más común de malaria en humanos, el P. vivax. Con lo que hemos averiguado sobre la estructura genética de ambos parásitos, podremos trasladar de forma más precisa nuestros estudios sobre el P. knowlesi a otros parásitos humanos. Y lo que no es menos importante, el genoma nos ayudará a comprender los casos humanos de malaria por knowlesi.» La investigación sobre el P. knowlesi fue financiada por el proyecto comunitario BioMalPar («Biología y patología del parásito de la malaria»), financiado a su vez mediante el área temática «Ciencias de la vida, genómica y biotecnología para la salud» del Sexto Programa Marco (6PM), y por el proyecto comunitario VIRIMAL («Estructura, función y potencial de vacunación de la familia multigénica vir en la malaria»), financiado a su vez por el programa específico «Calidad de vida y gestión de recursos vivos» del Quinto Programa Marco (5PM).